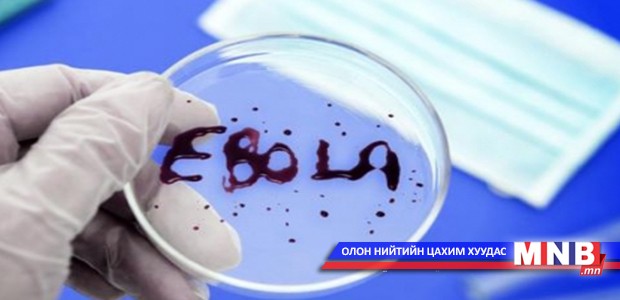

Оросын Риа-Новостигийн мэдээлснээр тус улсын Орёл хотын их сургуульд суралцахаар ирсэн Африкийн хоёр оюутан эбола вирусын халдвартай байж болзошгүй гэнэ. Баруун Африкийн Гвиней-Биссау улсаас ирсэн 20 настай Монтеро Болде, 23 настай Монтеро Аюук гэх хоёр оюутанд эбола вирусын халдвартай төстэй шинж тэмдэг илэрсэн тул бусдаас тусгаарлан эмнэлэгт хөл хорьжээ. Монтерогийн эгч дүүс 37.3 С хүрч халуурсан нь эбола вирусын халдвар гэж сэжиглэх үндэс болсон аж. Тэд өнгөрсөн лхагва гарагт Москва хотын Домодедово нисэх буудалд газардсан байна.
| Орост сурахаар ирсэн Африк оюутнуудаас эболагийн шинж тэмдэг илэрчээ | ||
| Үзсэн: 1293 | Mongolian National Broadcaster |


 Үндэсний телевиз
Үндэсний телевиз


















































































































 Лханаагийн Мөнхтөр
Лханаагийн Мөнхтөр

 Р.Слава
Р.Слава

 Б.Цоожчулуунцэцэг
Б.Цоожчулуунцэцэг





Сэтгэгдэл бичих:
АНХААРУУЛГА: Уншигчдын бичсэн сэтгэгдэлд MNB.mn хариуцлага хүлээхгүй болно. ТА сэтгэгдэл бичихдээ хууль зүйн болон ёс суртахууны хэм хэмжээг хүндэтгэнэ үү. Хэм хэмжээг зөрчсөн сэтгэгдэлийг админ устгах эрхтэй. Сэтгэгдэлтэй холбоотой санал гомдолыг 70127055 утсаар хүлээн авна.